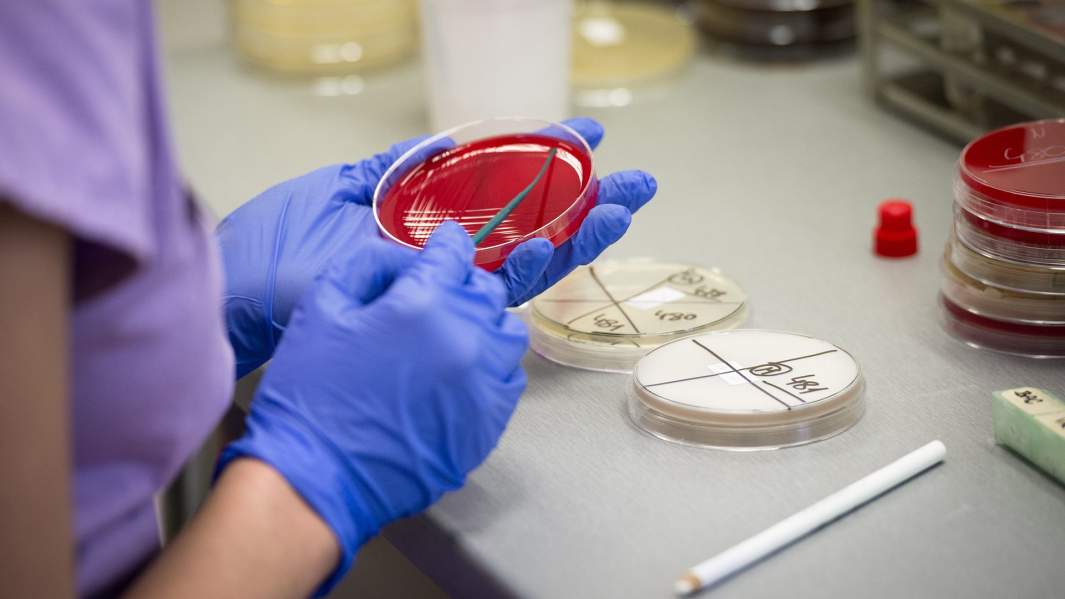
Тест на выявление коронавируса в пражской лаборатории

Лицо со штаммом: с вирусом хотят бороться лекарствами от шизофрении и бесплодия

За минувшие сутки в мире выявили более 800 новых случаев заражения коронавирусом 2019-nCoV. Пока заболевших не выявлено только на трех континентах: в Южной Америке, Африке и Антарктиде. 27 января Всемирная организация здравоохранения (ВОЗ) повысила уровень международной опасности нового вируса и призвала ученых всего мира начать работу над средством для его лечения. В Китае для борьбы с 2019-nCoV уже тестируют препараты от ВИЧ и шизофрении, а также народные средства от кашля и женского бесплодия. Роспотребнадзор пока отрицает наличие заболевших в нашей стране, однако глава правительства РФ уже поручил за два дня разработать план профилактики распространения инфекции. Тем временем авиабилеты в Китай резко дешевеют, а туристы спешат заменить путевки в КНР на Кубу, ОАЭ и Турцию.
800 случаев за день
Количество случаев заболевания китайским коронавирусом к понедельнику стремительно увеличилось. Роспотребнадзор РФ заявил о 2783 больных в Китае с официально подтвержденным диагнозом (в субботу, по данным Минздрава РФ, их было 1438), из которых 461 находится в тяжелом состоянии. Число жертв 2019-nCoV достигло 81 (в субботу их было 42). При этом 52 человека выздоровели.
Глава Роспотребнадзора Анна Попова отметила, что в понедельник коэффициент прироста заболеваемости коронавирусом снизился с 1,5 до 1,3. Однако счетчик китайского издания South China Morning Post вечером 27 января сообщил о 2901 случае по всему миру (в воскресенье вечером их было 2082). 2839 из них зарегистрированы на материковой территории Китая, восемь в Гонконге, семь в Макао, пять в Тайване и еще 28 в других странах Азии. Известно также о трех случаях заражения в Европе, шести в Северной Америке и пяти в Австралии. По данным ВОЗ, кроме Китая случаев передачи заболевания от человека к человеку пока не было — все они «завозные».
Власти разных стран принимают всё новые и новые меры защиты населения. Испания и Франция заявили об экстренном вывозе своих граждан из Уханя. Малайзия ввела временный запрет на посещение страны для жителей этого китайского города и провинции Хубэй. Казахстан приостановил действие 72-часовой транзитной визы для владельцев паспортов КНР. В Монголии, чтобы сдержать эпидемию, решили до 2 марта отсрочить начало учебного семестра. Кроме того, с 27 января Улан-Батор закрыл пограничные пункты для автомобилей и пешеходов из Китая.
Представитель ВОЗ в РФ Мелита Вуйнович рассказала «Известиям», что гендиректор организации находится в Китае. По ее словам, число заболевших увеличивается еще и за счет активной информационной работы, поэтому граждане начали чаще обращаться в медучреждения.
Пока решение чрезвычайного комитета не объявлять режим ЧС, принятое 23 января, остается в силе. Однако на последнем заседании, 26 января, ВОЗ исправила оценку риска распространения нового коронавируса на международном уровне с умеренного на повышенный.
Лекарства от ВИЧ и китайская медицина
В России пока не подтвержден ни один случай китайского коронавируса. По словам Анны Поповой, с 31 декабря было проверено более 1,3 млн человек, из которых выявили более 100 «подозреваемых», но 2019-nCoV у них не обнаружен.
Премьер-министр Михаил Мишустин 27 января поручил в течение двух дней подготовить план профилактики распространения инфекции, а президент страны будет на регулярной основе получать доклады по мониторингу ситуации с коронавирусом, говорится в сообщении правительства.
Тем временем ВОЗ призвала фармпроизводителей и ученых всего мира начать работу над противовирусными препаратами. Сейчас китайские медики для лечения нового типа коронавируса тестируют лекарства от ВИЧ. Так, в опубликованной научной статье о ходе лечения в больницах города Ухань сказано, что в качестве терапии будет использована комбинация препаратов лопинавир и ритонавир. Как пояснил «Известиям» заведующий инфекционным отделением университетской клиники РУДН Данила Коннов, эти средства терапии вируса иммунодефицита использовались и во время пандемии SARS в 2002–2003 годах.
— Их эффективность была продемонстрирована лабораторно и на небольшой группе пациентов, заразившихся коронавирусом SARS-CoV. Однако утверждать, что это сработает сейчас, нельзя, — отметил эксперт.
Ранее специалисты КНР изучили представленные на рынке лекарства и базы соединений, полученных из лекарственных растений. В итоге были выявлены 30 препаратов и средств китайской медицины, которые потенциально могли бы оказывать лечебное действие против коронавируса. Среди них оказалось и десять препаратов от ВИЧ.
— Китайские медики работают в полевых условиях, когда нет времени на исследования, а действовать нужно прямо сейчас, — пояснил «Известиям» член президиума Лиги здоровья нации Геннадий Онищенко. — Если с помощью рекомендованных препаратов спасут человеческие жизни, это будет большим достижением.
Также в списке оказались препарат, назначаемый при шизофрении, иммунодепрессант, лекарства против респираторно-синцитиального вируса, интерферон и другие средства. Из средств китайской традиционной медицины ученые выделили горец остроконечный, который применяют для лечения кашля, и эухресту японскую (ее используют в качестве средства от женского бесплодия). Специалисты предложили рассмотреть возможность провести клинические испытания всех этих средств на зараженных.
Однако признанных фармацевтическим сообществом препаратов от любых коронавирусов не существует, сообщил «Известиям» инфекционист-вакцинолог Евгений Тимаков. Нужны лабораторные, доклинические и клинические испытания.
— Если говорить о препаратах, которые потенциально можно использовать против коронавирусов, их отложенное действие и побочные эффекты пока не изучены, — пояснил эксперт. — Поэтому во всем мире они не применяются.
Китай заменили на Кубу
В связи со вспышкой коронавируса в Китае россияне, уже купившие путевки, решили не отказываться от отдыха и выбирают другое направление. По данным туроператоров, в лидерах сейчас Объединенные Арабские Эмираты, Куба и Турция.
— Перебронирование является наиболее востребованным решением, поскольку большинство туристов предпочитают сохранить свой отпуск. За выходные наиболее частой альтернативой были Куба и ОАЭ, — уточнили в туркомпании Anex Tour.
В ТEZ Tour также подтвердили, что основная масса туристов не отказывается от запланированного отдыха и предпочитает заменить поездку в Китай на другие зимние пляжные направления. При этом в настоящее время в КНР находится порядка 7–8 тыс. наших туристов, отметил вице-президент Российского союза туриндустрии (РСТ) Юрий Барзыкин. 80% из них отдыхают на Хайнане, уточнил он.
По словам директора «Турпомощи» Александра Осауленко, никаких жалоб от находящихся в Китае российских туристов не поступает. Оснований для вывоза всех российских туристов пока нет, уверен и председатель Общественного совета при Ростуризме Дмитрий Давыденко.
— Там, где находятся наши туристы, очагов эпидемиологической опасности не зафиксировано. А если учесть, что Китай не самое массовое направление, то ущерб для туркомпаний, скорее всего, будет незначительным, — предположил он.
Россияне посещают Китай не только как туристы, но и с деловыми визитами. По данным ФСБ, за три квартала прошлого года в рамках деловых поездок в КНР побывали 42 тыс. граждан РФ, а за весь 2018-й — 60 тыс.
Законодательство позволяет сотрудникам отказаться от командировки, пояснили «Известиям» в пресс-службе Роструда. Некоторых работников можно направлять в деловые поездки только в случае, если они дали согласие. В частности, речь идет о матерях детей младше трех лет, одиноких родителях и опекунах детей до пяти лет, родителях детей-инвалидов и людях, ухаживающих за больным членом семьи. Все они имеют право отказаться от командировки в силу закона, сказали в Роструде.
Ряд сотрудников вообще нельзя отправлять в деловые поездки, добавили в службе. В их число входят, например, беременные, а также работники, заключившие ученический договор, и инвалиды (если ограничение есть в индивидуальной программе реабилитации). В целом же отказаться от командировки может любой работник, если основания для этого предусмотрены в Трудовом кодексе или трудовом договоре, добавили в пресс-службе ведомства.
Вирусный спрос
На фоне снижения спроса билеты в Китай начали дешеветь, следует из данных, предоставленных «Известиям» Aviasales (анализировались бронирования 20–26 января). С 24 января аналитики зафиксировали снижение среднего чека на 12% — до 20 тыс. рублей. По данным Aviasales, сильнее всего подешевели перелеты в Пекин: снижение чека здесь достигло 30%, а спрос упал на 35%. Также снизились цены на полеты из России в Циндао и Ханчжоу.
В «Туту.ру» «Известиям» сказали, что доля путешественников в КНР, бронирующих билеты через сервис, «остается стабильной». Доля возвратов за предыдущие один-два года в среднем составляла примерно 4%. В январе-феврале она традиционно выше, но в этом году уже достигла 8%.
— К концу января мы ожидаем, что доля возвратов превысит показатели прошлого года, — добавила представитель сервиса.
Она также напомнила, что многие авиакомпании уже уведомили о готовности вернуть билеты — например, Beijing Capital, China Southern, China Eastern, Hainan Airlines и другие. К ним присоединились и российские перевозчики: «Аэрофлот», S7 Airlines и «Уральские авиалинии». Последняя компания с 27 января полностью остановила полеты в КНР. Также поступили AZUR air (партнер туроператора ANEX Tour), Nordwind и iFly (сотрудничает с TEZ Tour). В AZUR air «Известиям» сообщили, что намерены вывезти порядка 2 тыс. отдыхающих с острова Хайнань до 3 февраля. В Nordwind отметили, что обслуживали только китайских туристов, которые сейчас в плановом порядке уезжают домой — в Гуанчжоу и Ханчжоу.
По мнению источника «Известий» на авиарынке, финансовые потери чартерных компаний будут небольшими. В зоне риска находятся крупные авиаперевозчики, выполняющие регулярные рейсы на этом направлении — например, «Аэрофлот» и S7. Они действительно могут потерять часть трансферного потока, если Россия решит ограничить перевозки, полагает исполнительный директор агентства «Авиапорт» Олег Пантелеев. По мнению эксперта, поддержать отечественных перевозчиков в ситуации свертывания китайского туристического рынка могло бы открытие полетов в Египет.
За Китайской стеной
С самого начала эпидемии одним из главных способов остановить дальнейшее распространение вируса стала ставка властей КНР на максимальное ограничение передвижений. Правительство сообщило о продлении на три дня новогодних каникул (выход на работу перенесли с 31 января на 3 февраля), чтобы люди, уехавшие на праздники в другие города, воздержались от возвращения домой. Все учебные заведения большинства крупных городов — от детсадов до университетов — отсрочили начало занятий на неопределенный период. В стране был введен запрет на групповые туры как внутри Китая, так и за рубеж.
Одной из главных проблем страны стал дефицит защитных масок. Более 30 предприятий по их производству вызвали сотрудников из новогодних отпусков. Работа ведется по 24 часа в сутки в три смены, рассказали Global Times в компании «Медицинские товары Канлиди».
— На днях в Пекине произошел скандал: в отдельных аптеках маски стали продавать по 500 юаней (порядка 5 тыс. рублей) за 10 штук при обычной цене один-два юаня за маску, — рассказал «Известиям» живущий в Китае с 2003 года россиянин Алексей. — Власти оперативно пресекли это за счет жестких наказаний вплоть до отзыва лицензий, но теперь спекулировать на продаже масок стали частники.
По словам собеседника «Известий», особой паники в столице нет: улицы Пекина пустынны, но связано это не столько со вспышкой коронавируса, сколько с новогодними праздниками.
Охватившая страну эпидемия, пока обошедшая стороной лишь высокогорный Тибет, сказалась и на экономике. Уже в первый день китайского нового года (25 января) объем авиа- и железнодорожных перевозок сократился на 40% по сравнению с аналогичным периодом 2019-го. С учетом того, что эти отрасли получают около 16% доходов именно в зимний период, продолжение 40-процентного падения спроса на их услуги в течение недели приведет к потерям в 64 млрд юаней ($9,2 млрд), сказали «Известиям» аналитики информационного портала Plenum. Еще 100 млрд юаней ($14,4 млрд) рискует недополучить индустрия общественного питания и вдвое больше — туриндустрия.
— По нашим приблизительным оценкам, меры по сдерживанию вируса могут привести к замедлению экономического роста на четыре процентных пункта в I квартале 2020 года. Но за этим — после того как вирус окажется под контролем и страна вернется к нормальной жизни — должен последовать подъем, — отметили в Plenum.
Вирус заразил экономику
Коронавирус уже влияет на курсы национальных валют развивающихся рынков: на фоне неопределенности за неделю (с прошлого понедельника) рубль ослабился более чем на 1,5%, отметил инвестиционный стратег «БКС Премьер» Александр Бахтин. По его оценкам, в ближайшие дни падение может дойти до уровней, близких к 63 рублям за доллар. В перспективе первого полугодия 2020-го российская валюта будет находиться в диапазоне 63–65 рублей по отношению к доллару.
Юань с прошлого понедельника ослаб на 1,3%, однако сейчас движение валюты сложно оценить из-за праздников — на данный момент торги приостановлены, пояснил Александр Бахтин. По его ожиданиям, после возобновления торгов китайская валюта может превысить уровень 7 юаней за доллар с текущего 6,93 — то есть ослабнуть еще на 2%.
По словам аналитика, цена нефти Brent за этот же период уменьшилась с почти $64 до уровня ниже $59 за баррель. Если китайская тема повлечет дальнейший пессимизм, котировки в течение ближайших дней могут упасть до $55–57. Но при позитивном сценарии, если вирус купируют и остановят распространение, нефть может отыграть позиции и вернуться к цене $63–65 за баррель.
При негативном сценарии экономика России может показать нулевой рост в 2020 году, считает аналитик управления операций на российском фондовом рынке ИК «Фридом Финанс» Александр Осин. Он подчеркнул, что вероятность реализации этого сценария всего 20%. Базовый же прогноз изменения ВВП в нынешнем году остается прежним — повышение на 2–2,5%.
Стремительное распространение коронавируса с большой вероятностью отразится и на мировом ВВП, поскольку КНР выступает одной из самых крупных и быстрорастущих экономик, считают эксперты. Рост мировой экономики при этом составит 2,5–2,8%, тогда как в прошлом году он увеличился на 2,9%, напомнил Александр Осин.
Над материалом работали: Елена Сидоренко, Ярослава Костенко, Мария Недюк, Наталия Портякова, Наталья Ильина, Анна Ивушкина, Александр Волобуев